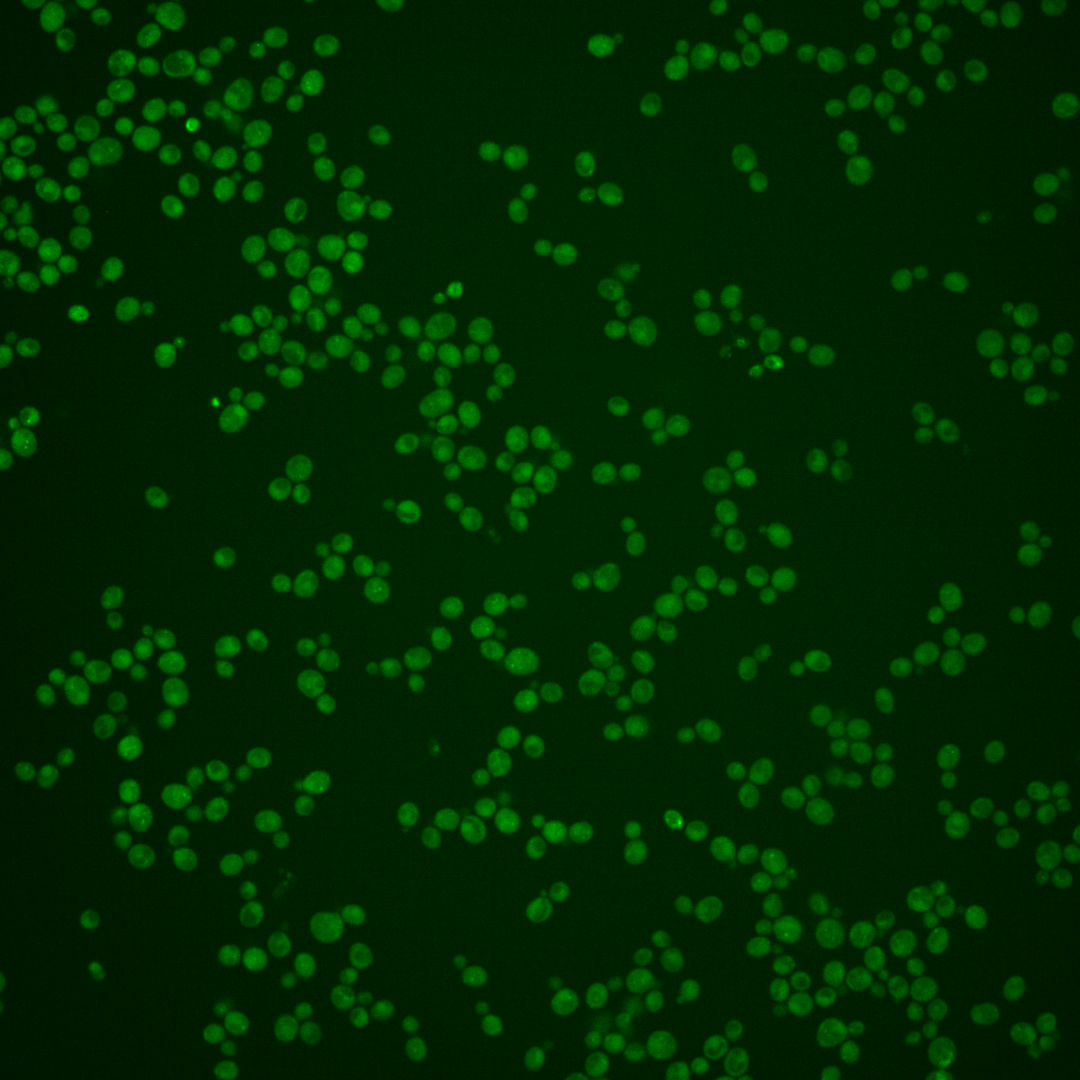
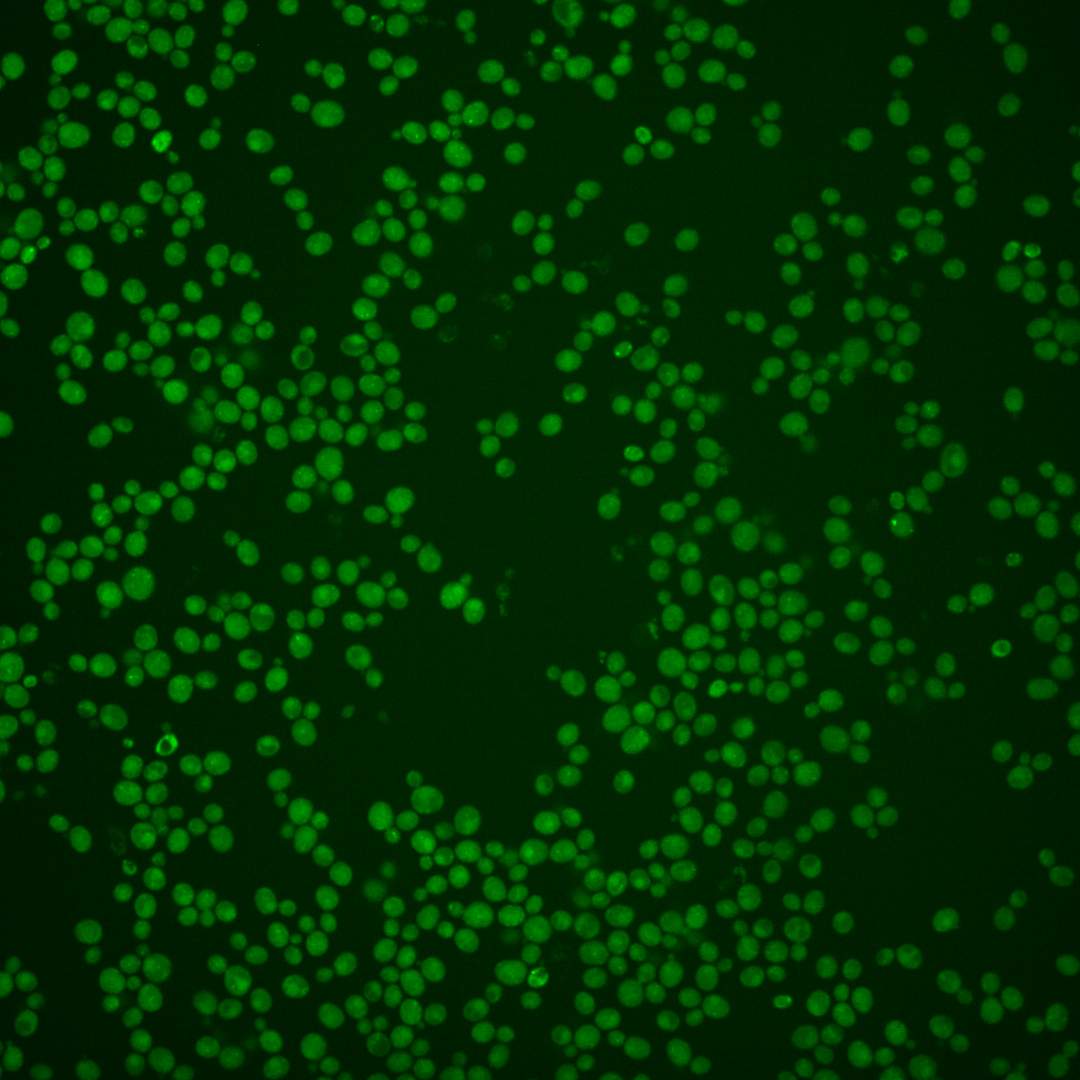
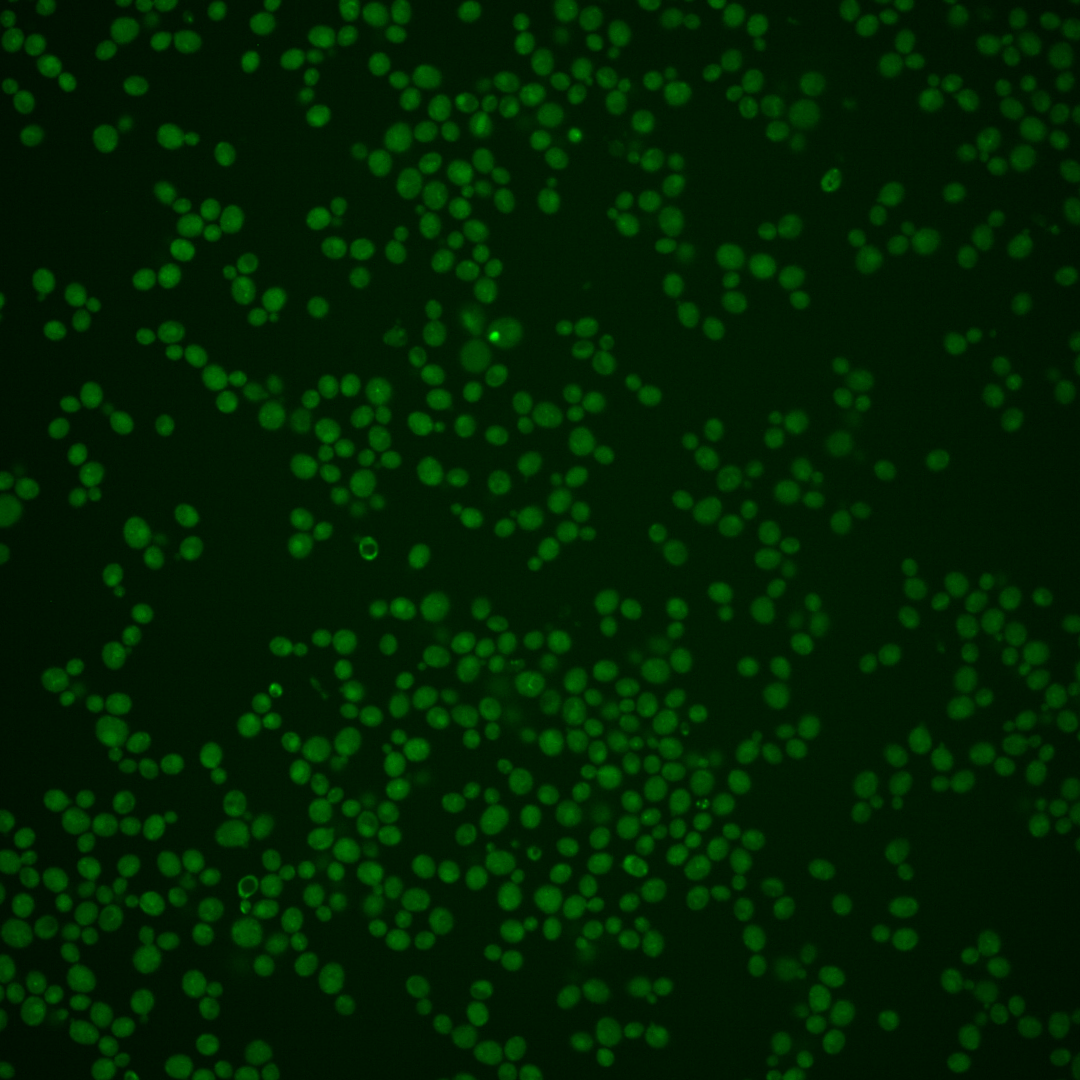
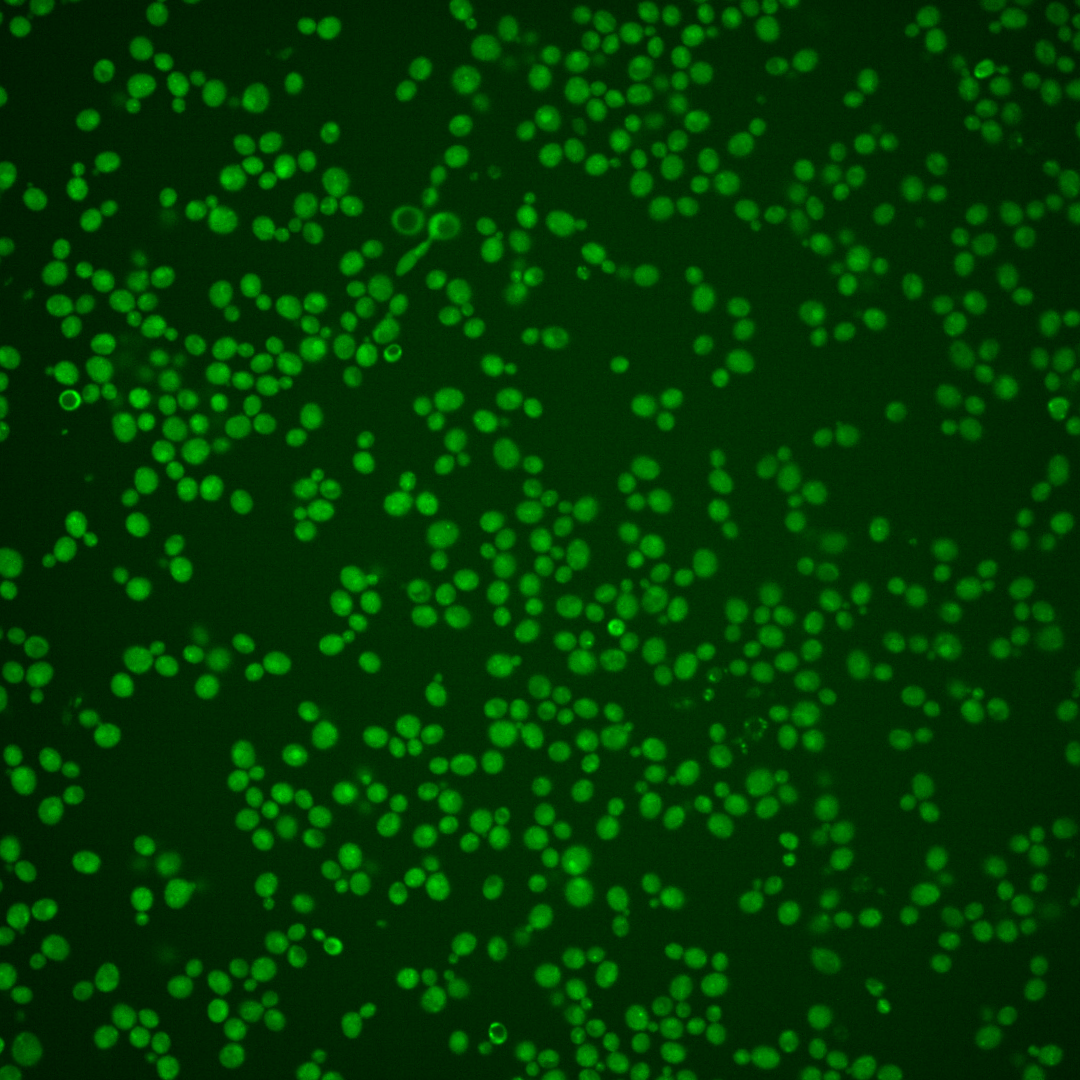

| Standard name | |
|---|---|
| Human Ortholog | |
| Description | Peptidyl-prolyl cis-trans isomerase (cyclophilin); catalyzes the cis-trans isomerization of peptide bonds N-terminal to proline residues; has a potential role in the secretory pathway; CPR4 has a paralog, CPR8, that arose from the whole genome duplication |
Micrographs




















































































Sub-cellular Localization
Yeast GFP Assignment
Protein Abundance
Localization Change
External localization resources
| ensLOC | DeepLoc | |||||||||||||||||||||||
|---|---|---|---|---|---|---|---|---|---|---|---|---|---|---|---|---|---|---|---|---|---|---|---|---|
| Localization | WT1 | WT2 | WT3 | RAP60 | RAP140 | RAP220 | RAP300 | RAP380 | RAP460 | RAP540 | RAP620 | RAP700 | HU80 | HU120 | HU160 | rpd3Δ_1 | rpd3Δ_2 | rpd3Δ_3 | WT1 | WT2 | WT3 | AF100 | AF140 | AF180 |
| Cortical Patches | 0 | 0 | 0 | 0 | 0 | 0 | 0 | 0 | – | 0 | 0 | 2 | 0 | 0 | 2 | 0 | 0 | 0 | 0 | 1 | 1 | 0 | 0 | 0 |
| Bud | 0 | 3 | 0 | 2 | 10 | 14 | 11 | 6 | – | 9 | 34 | 35 | 1 | 1 | 3 | 0 | 0 | 0 | 0 | 2 | 1 | 0 | 1 | 0 |
| Bud Neck | 0 | 0 | 0 | 0 | 0 | 0 | 0 | 0 | – | 1 | 0 | 0 | 0 | 0 | 1 | 0 | 0 | 0 | 0 | 0 | 0 | 0 | 0 | 2 |
| Bud Site | 0 | 0 | 0 | 0 | 0 | 0 | 0 | 1 | – | 0 | 1 | 0 | 0 | 0 | 0 | 0 | 0 | 0 | – | – | – | – | – | – |
| Cell Periphery | 0 | 1 | 0 | 0 | 1 | 1 | 0 | 2 | – | 1 | 1 | 1 | 0 | 0 | 3 | 0 | 0 | 0 | 0 | 0 | 0 | 0 | 0 | 0 |
| Cytoplasm | 28 | 70 | 82 | 359 | 690 | 818 | 1044 | 1028 | – | 1142 | 801 | 971 | 28 | 80 | 190 | 87 | 71 | 71 | 2 | 17 | 7 | 1 | 12 | 15 |
| Endoplasmic Reticulum | 0 | 2 | 3 | 0 | 1 | 1 | 1 | 1 | – | 0 | 1 | 2 | 0 | 1 | 2 | 15 | 13 | 6 | 1 | 2 | 9 | 0 | 3 | 1 |
| Endosome | 0 | 4 | 1 | 7 | 17 | 6 | 10 | 21 | – | 17 | 7 | 4 | 0 | 1 | 0 | 15 | 7 | 6 | 0 | 6 | 2 | 0 | 2 | 4 |
| Golgi | 0 | 0 | 0 | 0 | 0 | 0 | 0 | 0 | – | 0 | 0 | 0 | 0 | 0 | 0 | 2 | 1 | 0 | 0 | 0 | 1 | 1 | 0 | 1 |
| Mitochondria | 9 | 0 | 9 | 5 | 16 | 87 | 61 | 27 | – | 85 | 110 | 185 | 0 | 1 | 0 | 9 | 4 | 3 | 1 | 2 | 1 | 0 | 4 | 4 |
| Nucleus | 11 | 2 | 0 | 6 | 1 | 15 | 15 | 17 | – | 9 | 3 | 7 | 0 | 1 | 0 | 72 | 45 | 33 | 3 | 0 | 0 | 0 | 0 | 1 |
| Nuclear Periphery | 0 | 1 | 0 | 0 | 4 | 2 | 11 | 11 | – | 2 | 0 | 4 | 0 | 0 | 0 | 0 | 2 | 0 | 0 | 0 | 0 | 0 | 0 | 1 |
| Nucleolus | 0 | 0 | 0 | 0 | 0 | 2 | 1 | 5 | – | 1 | 1 | 4 | 0 | 1 | 0 | 0 | 0 | 0 | 0 | 0 | 0 | 0 | 0 | 0 |
| Peroxisomes | 0 | 0 | 0 | 0 | 0 | 0 | 0 | 2 | – | 0 | 0 | 0 | 0 | 0 | 0 | 0 | 0 | 0 | 0 | 0 | 0 | 0 | 0 | 0 |
| SpindlePole | 0 | 0 | 0 | 0 | 0 | 2 | 0 | 5 | – | 3 | 2 | 1 | 0 | 0 | 1 | 0 | 0 | 1 | 0 | 1 | 0 | 0 | 0 | 0 |
| Vac/Vac Membrane | 47 | 79 | 56 | 208 | 240 | 192 | 216 | 126 | – | 111 | 87 | 81 | 8 | 13 | 3 | 176 | 175 | 164 | 96 | 127 | 125 | 18 | 74 | 118 |
| Unique Cell Count | 79 | 140 | 132 | 464 | 843 | 986 | 1202 | 1141 | 1250 | 912 | 1134 | 34 | 92 | 199 | 287 | 259 | 235 | 107 | 166 | 152 | 26 | 107 | 152 | |
| Labelled Cell Count | 95 | 162 | 151 | 587 | 980 | 1140 | 1370 | 1252 | 1381 | 1048 | 1297 | 37 | 99 | 205 | 376 | 318 | 284 | 107 | 166 | 152 | 26 | 107 | 152 | |
Yeast GFP Assignment
Protein Abundance
| Screen | WT1 | WT2 | WT3 | RAP60 | RAP140 | RAP220 | RAP300 | RAP380 | RAP460 | RAP540 | RAP620 | RAP700 | HU80 | HU120 | HU160 | rpd3Δ_1 | rpd3Δ_2 | rpd3Δ_3 | AF100 | AF140 | AF180 |
|---|---|---|---|---|---|---|---|---|---|---|---|---|---|---|---|---|---|---|---|---|---|
| Mean Cell GFP Intensity (1e-4) | 5.5 | 7.0 | 5.7 | 6.3 | 6.1 | 4.6 | 4.2 | 4.8 | – | 3.9 | 3.9 | 3.6 | 6.7 | 6.6 | 4.9 | 8.6 | 8.4 | 8.8 | – | 7.6 | 7.4 |
| Std Deviation (1e-4) | 1.2 | 1.8 | 1.2 | 1.7 | 1.5 | 1.5 | 1.3 | 5.5 | – | 1.1 | 0.9 | 0.8 | 1.4 | 2.0 | 1.0 | 2.0 | 1.9 | 2.0 | – | 2.5 | 1.5 |
| Intensity Change (Log2) | – | – | – | 0.14 | 0.09 | -0.29 | -0.45 | -0.26 | – | -0.54 | -0.56 | -0.67 | 0.24 | 0.21 | -0.22 | 0.59 | 0.56 | 0.64 | – | 0.42 | 0.38 |
Localization Change
| Localization | RAP60 | RAP140 | RAP220 | RAP300 | RAP380 | RAP460 | RAP540 | RAP620 | RAP700 | HU80 | HU120 | HU160 | rpd3Δ_1 | rpd3Δ_2 | rpd3Δ_3 |
|---|---|---|---|---|---|---|---|---|---|---|---|---|---|---|---|
| Cortical Patches | 0 | 0 | 0 | 0 | 0 | – | 0 | 0 | 0 | 0 | 0 | 0 | 0 | 0 | 0 |
| Bud | 0 | 0 | 0 | 0 | 0 | – | 0 | 0 | 0 | 0 | 0 | 0 | 0 | 0 | 0 |
| Bud Neck | 0 | 0 | 0 | 0 | 0 | – | 0 | 0 | 0 | 0 | 0 | 0 | 0 | 0 | 0 |
| Bud Site | 0 | 0 | 0 | 0 | 0 | – | 0 | 0 | 0 | 0 | 0 | 0 | 0 | 0 | 0 |
| Cell Periphery | 0 | 0 | 0 | 0 | 0 | – | 0 | 0 | 0 | 0 | 0 | 0 | 0 | 0 | 0 |
| Cytoplasm | 3.5 | 5.2 | 5.7 | 7.4 | 9.1 | – | 10.0 | 7.6 | 6.8 | 2.2 | 4.1 | 7.8 | -6.2 | -6.7 | -5.9 |
| Endoplasmic Reticulum | 0 | 0 | 0 | 0 | 0 | – | 0 | 0 | 0 | 0 | 0 | 0 | 1.4 | 1.3 | 0 |
| Endosome | 0 | 0 | 0 | 0 | 0 | – | 0 | 0 | 0 | 0 | 0 | 0 | 2.2 | 0 | 0 |
| Golgi | 0 | 0 | 0 | 0 | 0 | – | 0 | 0 | 0 | 0 | 0 | 0 | 0 | 0 | 0 |
| Mitochondria | 0 | 0 | 0 | 0 | 0 | – | 0 | 0 | 0 | 0 | 0 | 0 | -1.7 | 0 | 0 |
| Nucleus | 0 | 0 | 0 | 0 | 0 | – | 0 | 0 | 0 | 0 | 0 | 0 | 6.3 | 5.1 | 4.5 |
| Nuclear Periphery | 0 | 0 | 0 | 0 | 0 | – | 0 | 0 | 0 | 0 | 0 | 0 | 0 | 0 | 0 |
| Nucleolus | 0 | 0 | 0 | 0 | 0 | – | 0 | 0 | 0 | 0 | 0 | 0 | 0 | 0 | 0 |
| Peroxisomes | 0 | 0 | 0 | 0 | 0 | – | 0 | 0 | 0 | 0 | 0 | 0 | 0 | 0 | 0 |
| SpindlePole | 0 | 0 | 0 | 0 | 0 | – | 0 | 0 | 0 | 0 | 0 | 0 | 0 | 0 | 0 |
| Vacuole | 0.5 | -3.2 | -6.0 | -6.6 | -9.8 | – | -11.2 | -10.3 | -12.3 | -2.0 | -4.5 | -9.5 | 3.6 | 4.8 | 5.1 |
External localization resources
Images






























Protein Concentration and Protein Localization Data
| R1 | R2 | R3 | ||||||||||||||||
|---|---|---|---|---|---|---|---|---|---|---|---|---|---|---|---|---|---|---|
| G1 Pre-START | G1 Post-START | S/G2 | Metaphase | Anaphase | Telophase | G1 Pre-START | G1 Post-START | S/G2 | Metaphase | Anaphase | Telophase | G1 Pre-START | G1 Post-START | S/G2 | Metaphase | Anaphase | Telophase | |
| Concentration | 1.3488 | 2.5788 | 2.3337 | 2.2982 | 1.9309 | 2.2575 | 0.9201 | 2.2985 | 1.9226 | 1.9538 | 1.8098 | 1.9877 | -0.6899 | 0.9234 | 0.6612 | 0.2984 | 0.5667 | 0.5631 |
| Actin | 0.0096 | 0.0002 | 0.0096 | 0.0036 | 0.0212 | 0.0008 | 0.0223 | 0.0002 | 0.0075 | 0.0324 | 0.005 | 0.006 | 0.0171 | 0.0001 | 0.0001 | 0 | 0 | 0 |
| Bud | 0.001 | 0.0019 | 0.0016 | 0.002 | 0.0006 | 0.0041 | 0.0005 | 0.0008 | 0.0009 | 0.0008 | 0.0004 | 0.0005 | 0.0003 | 0.0003 | 0.0004 | 0.0005 | 0.0002 | 0.0002 |
| Bud Neck | 0.0024 | 0.0041 | 0.0018 | 0.0016 | 0.0016 | 0.0038 | 0.0014 | 0.0041 | 0.0006 | 0.001 | 0.0013 | 0.0016 | 0.0004 | 0.0008 | 0.0003 | 0.0003 | 0.0004 | 0.0011 |
| Bud Periphery | 0.0028 | 0.0014 | 0.0038 | 0.0042 | 0.0008 | 0.003 | 0.0009 | 0.001 | 0.0016 | 0.0006 | 0.0006 | 0.001 | 0.0005 | 0.0005 | 0.0005 | 0.0012 | 0.0001 | 0.0003 |
| Bud Site | 0.0034 | 0.0143 | 0.0049 | 0.0044 | 0.0022 | 0.004 | 0.0018 | 0.0071 | 0.0019 | 0.0021 | 0.0011 | 0.0009 | 0.0014 | 0.0013 | 0.0015 | 0.0005 | 0.0005 | 0.0003 |
| Cell Periphery | 0.0015 | 0.0013 | 0.0011 | 0.0006 | 0.0004 | 0.0009 | 0.0009 | 0.002 | 0.0013 | 0.0004 | 0.0007 | 0.0009 | 0.0006 | 0.0007 | 0.0006 | 0.0003 | 0.0002 | 0.0004 |
| Cytoplasm | 0.0859 | 0.1851 | 0.1341 | 0.0345 | 0.104 | 0.1266 | 0.1075 | 0.1855 | 0.1572 | 0.0945 | 0.1304 | 0.1598 | 0.1771 | 0.2226 | 0.2267 | 0.1155 | 0.0236 | 0.177 |
| Cytoplasmic Foci | 0.057 | 0.0645 | 0.0528 | 0.0555 | 0.0527 | 0.0354 | 0.0587 | 0.0359 | 0.0426 | 0.044 | 0.0429 | 0.0352 | 0.0445 | 0.0259 | 0.0315 | 0.0206 | 0.0109 | 0.0187 |
| Eisosomes | 0.0003 | 0.0001 | 0.0008 | 0.0001 | 0.0002 | 0 | 0.0002 | 0.0001 | 0.0002 | 0.0003 | 0 | 0.0001 | 0.0001 | 0 | 0 | 0 | 0 | 0 |
| Endoplasmic Reticulum | 0.0202 | 0.0125 | 0.0168 | 0.0026 | 0.0097 | 0.0086 | 0.0214 | 0.0192 | 0.0275 | 0.0061 | 0.0062 | 0.0158 | 0.0449 | 0.0247 | 0.0491 | 0.0304 | 0.0026 | 0.013 |
| Endosome | 0.2927 | 0.2094 | 0.2954 | 0.3744 | 0.302 | 0.2334 | 0.3026 | 0.2424 | 0.3158 | 0.4091 | 0.3434 | 0.2661 | 0.3164 | 0.2055 | 0.3042 | 0.3206 | 0.3755 | 0.2628 |
| Golgi | 0.0116 | 0.0037 | 0.0073 | 0.0168 | 0.0119 | 0.0045 | 0.0141 | 0.0055 | 0.0113 | 0.0081 | 0.0079 | 0.0069 | 0.0087 | 0.0025 | 0.0076 | 0.0058 | 0.0032 | 0.0026 |
| Lipid Particles | 0.0197 | 0.0111 | 0.0154 | 0.018 | 0.0226 | 0.0111 | 0.0185 | 0.013 | 0.0086 | 0.0056 | 0.0115 | 0.013 | 0.0151 | 0.0036 | 0.0071 | 0.0047 | 0.0007 | 0.0038 |
| Mitochondria | 0.0181 | 0.0025 | 0.0076 | 0.0133 | 0.0064 | 0.0051 | 0.0116 | 0.0027 | 0.0151 | 0.0023 | 0.003 | 0.0105 | 0.0042 | 0.0126 | 0.0067 | 0.0233 | 0.0003 | 0.0014 |
| None | 0.1467 | 0.1029 | 0.1044 | 0.0375 | 0.051 | 0.0485 | 0.1594 | 0.1098 | 0.1213 | 0.0382 | 0.0336 | 0.1017 | 0.1123 | 0.0749 | 0.0894 | 0.0277 | 0.0002 | 0.0148 |
| Nuclear Periphery | 0.0104 | 0.0109 | 0.0129 | 0.003 | 0.0088 | 0.0067 | 0.0167 | 0.0105 | 0.0149 | 0.0052 | 0.0048 | 0.0076 | 0.0162 | 0.0139 | 0.0188 | 0.0137 | 0.0037 | 0.0172 |
| Nucleolus | 0.0027 | 0.0045 | 0.0039 | 0.0017 | 0.0011 | 0.0019 | 0.0009 | 0.0014 | 0.001 | 0.0016 | 0.001 | 0.001 | 0.0008 | 0.0008 | 0.0007 | 0.0009 | 0.0004 | 0.0005 |
| Nucleus | 0.0099 | 0.0165 | 0.0063 | 0.0032 | 0.0106 | 0.0116 | 0.0042 | 0.0052 | 0.004 | 0.0054 | 0.0039 | 0.0049 | 0.0053 | 0.0063 | 0.0041 | 0.0052 | 0.002 | 0.0045 |
| Peroxisomes | 0.0107 | 0.0012 | 0.0058 | 0.0167 | 0.02 | 0.0078 | 0.0067 | 0.001 | 0.0019 | 0.003 | 0.022 | 0.0024 | 0.0046 | 0.0002 | 0.0003 | 0.0007 | 0.0001 | 0.0002 |
| Punctate Nuclear | 0.0107 | 0.0036 | 0.0027 | 0.0023 | 0.0019 | 0.001 | 0.0058 | 0.0009 | 0.0045 | 0.0057 | 0.0015 | 0.0008 | 0.0114 | 0.0006 | 0.0007 | 0.0006 | 0.0001 | 0.0002 |
| Vacuole | 0.2584 | 0.3273 | 0.2803 | 0.368 | 0.3348 | 0.4392 | 0.2243 | 0.3145 | 0.2197 | 0.3028 | 0.3444 | 0.325 | 0.1956 | 0.3715 | 0.2168 | 0.3556 | 0.5195 | 0.4172 |
| Vacuole Periphery | 0.0242 | 0.0211 | 0.0309 | 0.0362 | 0.0357 | 0.0419 | 0.0195 | 0.0373 | 0.0406 | 0.0308 | 0.0343 | 0.0384 | 0.0227 | 0.0305 | 0.033 | 0.0721 | 0.0558 | 0.0639 |
Sequencing Data
| R1 | R2 | |||||||||
|---|---|---|---|---|---|---|---|---|---|---|
| G1 Post-START | S/G2 | Metaphase | Anaphase | Telophase | G1 Post-START | S/G2 | Metaphase | Anaphase | Telophase | |
| Gene Expression | 70.9084 | 69.0566 | 67.3042 | 54.2269 | 56.8059 | 73.75 | 93.5317 | 96.0102 | 80.2232 | 56.517 |
| Translational Efficiency | 0.993 | 1.1505 | 0.8104 | 0.8462 | 0.8209 | 1.0978 | 0.9273 | 0.8557 | 0.8724 | 1.0102 |
Hit Data
| Dataset | Hit |
|---|---|
| Protein Concentration | ✔ |
| Protein Localization | ✘ |
| Gene Expression | ✔ |
| Translational Efficiency | ✘ |
Endocytosis
| Temp | Actin Patch (Sac6-tdTomato) | Cortical Patch (Sla1-GFP) | Late Endosome (Snf7-GFP) | Vacuole (Vph1-GFP) |
|---|---|---|---|---|
| 37℃ | ||||
| RT |
Cell Cycle Omics
CYCLoPs (Cpr4-GFP)
| Gene / Allele | Actin Patch (Sac6-tdTomato) | Cortical Patch (Sla1-GFP) | Late Endosome (Snf7-GFP) | Vacuole (Sac6-tdTomato) |
|---|
| Gene | Images |
|---|
| Gene | Images |
|---|
Images are not yet available
Images are not yet available